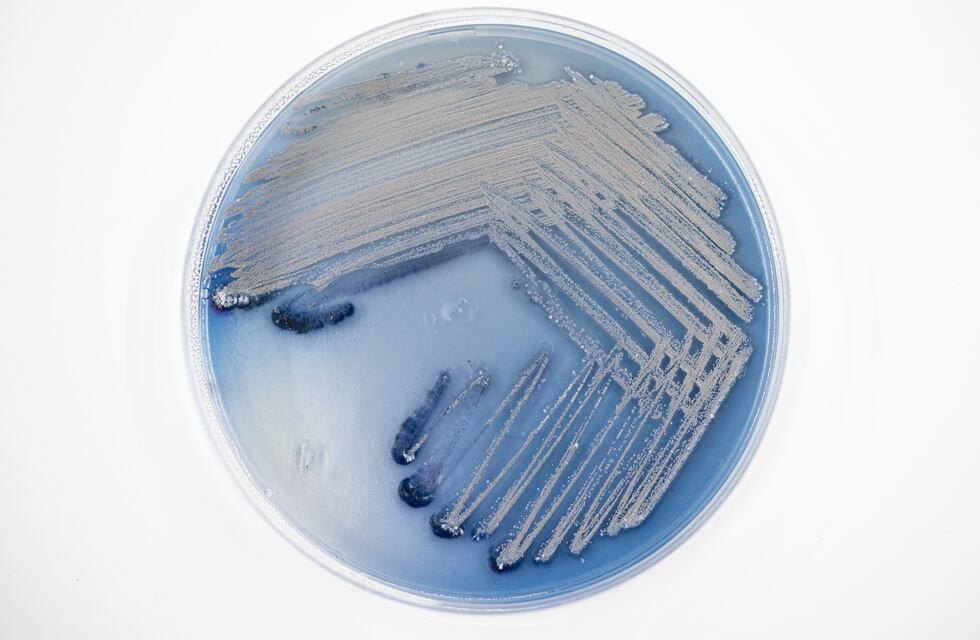
Tintte, el emprendimiento cordobés que resuelve un problema de contaminación mundial

Gustavo Freytes Garzón y Rodrigo Asili son dos cordobeses que se preocuparon por la contaminación del Lago San Roque. Tras una serie de investigaciones alrededor de esta inquietud, encontraron la solución a un problema local y mundial.
Gustavo había iniciado sus estudios para ser contador en la universidad, pero a pocas materias de recibirse se dio cuenta que no era lo suyo y apostó por el mundo del emprendedurismo.

“A los 20 y tantos, con un amigo abrimos una distribuidora de insumos gastronómicos para bares. Empezó como un juego hasta que llegamos a representar a importantes firmas”, recordó en diálogo con Vía Córdoba.
En 2020, Gustavo vendió la empresa porque empezó a tener intereses relacionados con el clima. “La distribución generaba mucha contaminación y la Municipalidad no recolectaba los empaques de los productos que quedaban en la calle”, recordó.
En ese marco, el hombre empezó a gestar una start up con la idea de reducir la basura en las calles, pero no siguió por falta de financiamiento. Con su alma de emprendedor, se metió en el mundo de la biotecnología gracias a Rodrigo Asili.

LA BIOTECNOLOGÍA Y SU IMPORTANCIA PARA EL MEDIO AMBIENTE
Rodrigo Asili, el compañero de Gustavo en este viaje, se formó en Río Cuarto como microbiólogo y comenzó con el desarrollo de un banco de microorganismos. ”Me sorprendió su capacidad para encontrar soluciones a problemas globales”, dijo Freytes sobre este nuevo universo.

De esta manera, ambos cordobeses se asociaron con Summabio, una empresa local que produce insumos para el agro. No obstante, nunca dejaron de buscar soluciones a problemas globales y, sin darse cuenta, fueron formulando algunas respuestas.
TINTTE Y LA INTENCIÓN DE DESCONTAMINAR EL SAN ROQUE
“Es un propósito de vida que nos mueve a emprender, nos moviliza y obliga a desarrollar tecnología que pueda resolver un problema que haga sentido”, explicó Gustavo sobre Tintte, el emprendimiento que surgió en diciembre de 2023 gracias al trabajo conjunto de Freytes, Asili y Magalí Mendez, que se sumó ese año.

Mientras ambos cordobeses trabajaban en Summabio, Asili estaba conformando un banco de microorganismos, los cuales progresaron hasta obtener diferentes funcionalidades y capacidades.
Una de las cualidades adquiridas por los microorganismos es la biorremediación. Se trata de la habilidad de eliminar compuestos que pueden llegar a ser tóxicos en ciertos ambientes y ecosistemas, según explicaron los profesionales.
De esta manera, los cordobeses encontraron una posible solución a la contaminación del lago San Roque. Intentaron bioremediar el cuerpo de agua, pero no encontraron la forma para hacerlo a gran escala. Sin embargo, no se quedaron de brazos cruzados y fueron a la raíz del problema.

TINTTE, LA INDUSTRIA TEXTIL Y LA APLICACIÓN DE LA SOLUCIÓN
Resulta que la industria textil es la segunda más contaminante para el agua a nivel mundial. “En Argentina no lo vemos, pero en otros lugares del Mundo, como India, es un problema super grave. Visualmente el río es de un color artificial y los químicos están a la vista”, contextualizó Gustavo.
En números, “un año de contaminación de esta industria equivale al agua que utilizarían dos países como Argentina”, comparó el cordobés. En la industria textil se necesitan aproximadamente 1.000 litros de agua para teñir una prenda y el 20 por ciento del agua del Mundo se contamina por la coloración.

El biobanco de Asili está compuesto por 100 microorganismos que generan colores y biocompuestos que se usan en el proceso de coloración. Ya fue probado en fase laboratorio y están trabajando para hacerlo a escala industrial.
A nivel técnico, Tintte desarrolló un proceso biotecnológico único para producir, depositar y fijar pigmentos en textiles. Ahora, hacen tintes petroquímicos y compuestos auxiliares utilizados en el proceso de coloración de la industria textil.

“Aplicamos la biotecnología a bacterias específicamente seleccionadas para producir biocolorantes y biocompuestos”, detalló Gustavo sobre el procedimiento que utiliza un 50 por ciento menos de agua y electricidad en comparación al tradicional.

Todo comenzó por una inquietud en la provincia de Córdoba y ahora se trata de una empresa con un propósito claro: reducir al máximo el uso y contaminación de agua potable en la industria.

Lo están logrando y en Tintte están en el proceso de levantamiento de capital para poder seguir desarrollándose. “Invitamos a marcas de indumentaria que quieran probar el concepto de tintes biodegradables con nosotros”, dijo.
El próximo objetivo de la firma es participar en un proceso de aceleración internacional, relacionado a la industria de la moda o clima tech para tener más visibilidad.
Por último, desde Tintte dejaron un mensaje de aliento para la científica: “La ciencia tiene un potencial enorme. La vinculación siempre es bienvenida y va a generar una economía del conocimiento super potente en Argentina”.